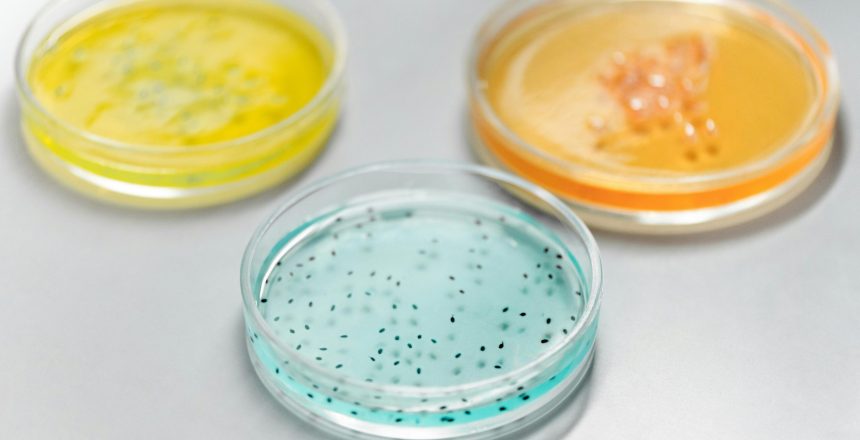
pexels-edward-jenner-4033023

La Legionella es el nombre que se da al conjunto de bacterias que viven en aguas estancadas a una temperatura superior a 35ºC y se desarrolla, debido a la presencia de materia orgánica. Existen 48 especies y un total de unos 78 serotipos, y algunas de ellas pueden infectar a humanos, en especial, la peligrosa Legionella pneumophila.
La legionelosis, puede presentarse con fiebre de carácter leve que no llega a afectar a los pulmones, lo que se conoce con el nombre de fiebre de Pontiac, o bien grave, que se focaliza en los pulmones se denomina enfermedad del legionario. Los principales síntomas son: fatiga, dificultad para respirar, diarrea, tos sanguinolenta o dolores musculares. En ocasiones puede llegar a ser mortal.
El sistema de aguas de grandes edificios, las fuentes de agua termal o el aire acondicionado son la mayor fuente de contagio de Legionella. Algunas personas han sido infectadas de legionella en bares y restaurantes. Los brotes suelen aparecer en los sistemas de aire acondicionado y distribución de agua, humidificadores y jacuzzis con mantenimiento deficiente.
Diagnóstico y tratamiento de la legionella
La Legionella es una Bacteria ambiental, y para su eliminación, es necesario recoger muestras y analizar los resultados y si son positivos, entonces hay que aplicar el tratamiento para erradicarla totalmente, afirman en Control Plag, una empresa especializada en tratamientos DDD, que destaca por su rigurosa seriedad, eficacia y puntualidad en todos y cada uno de sus trabajos, ayudando en la eliminación de plaga a todo tipo de clientes, desde colegios y hoteles, a particulares o tiendas de alimentación, pasando, incluso, por barcos de pesca y salvamento. En fin, que cualquiera que tenga un problema de plagas puede solicitar los servicios de Control Plag, ya sea por legionella, cucarachas, enfermedades de la madera, ratas, etc.
Para un diagnóstico eficaz es necesario un análisis microbiológico por alguna de las siguientes vías: demostración de antígenos en orina, hibridación con sondas moleculares específicas, cultivo en medio selectivo (BCYE-alpha agar + Antibióticos). Para su identificacións, se requiere una prueba de la catalasa y oxidasa.
La mayor parte de las personas expuestas a la bacteria causante no se pone enferma, y no se contagia directamente de persona a persona. Sin embargo, las personas mayores de
50 años, con sistema inmune débil o que padecen alguna enfermedad crónica, además de las personas que fuman y beben, corren mayor riesgo de padecerla.
No se sabe con exactitud si esta bacteria se da en unas zonas más que en otras, principalmente porque en algunas áreas, como en los países del tercer mundo, no cuentan con medios para un análisis y detección eficaces. Lo que sí se sabe es que en Australia, Europa y los Estados Unidos se dan entres 10 y 15 casos por millón de habitantes.
Para prevenir esta enfermedad, lo único que se puede hacer es limpiar y desinfectar, así como ofrecer un mantenimiento regular a los sistemas de aire acondicionado y distribución de agua a fin de minimizar el riesgo de desarrollo de esta bacteria. En la actualidad, no existen
contra la legionelosis.
Qué dice la ley
La legionela está legislada por el R.D. 865/2003, de 4 de julio, por el que se establecen los criterios higiénico-sanitarios para la prevención y control de la legionelosis, RD. 1027/2007, de 20 de julio, por el que se aprueba el Reglamento de Instalaciones Térmicas en los Edificios (RITE). RD. 140/2003, de 7 de febrero, por el que se establecen los criterios sanitarios de calidad del agua de consumo humano. (BOE núm. 170, de 17 de marzo), modificado en parte por el RD 902/2018. RD. 742/2013, de 27 de septiembre, por el que se establecen los criterios técnico-sanitarios de las piscinas. Además, la Norma UNE 100030:2017 IN constituye una Guía para la prevención y control de la proliferación y diseminación de legionella en instalaciones. Tal y como se establece en el artículo 6 del Real Decreto 865/2003 «Con carácter complementario se tendrá en cuenta lo establecido en la Norma UNE 100030 IN Guía para la prevención y control de la proliferación y diseminación de Legionella en instalaciones.»
Así pues, la limpieza y desinfección de grandes edificios y espacios públicos, así como las revisiones y controles periódicos, son de obligado cumplimiento por ley, a fin de evitar el desarrollo de esta y otra bacterias. La prevención, decíamos al comienzo, es el mejor tratamiento. En caso de dudas, no dejes de ponerte en contacto con Control Plag, su equipo de profesionales